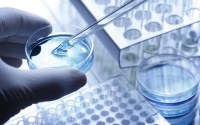
全套基因检测只要39.9，这家创业公司是怎么做到的？

互联网创业 - 科技快讯

又一小米生态链企业获亿元融资:杨华的创业思考,道出成功的真相
2021年05月11日 12:34

创业为何会失败?真正的原因找到了
2021年05月11日 09:40

36氪独家 | 前网易高管方锐创业,「元保」成立1年获数十亿元融资
2021年05月10日 08:16

芯片短缺催生创业热潮,去年芯片行业风投超120亿美元
2021年05月08日 13:54
海归创业者,如今没有优势了吗?
2021年04月30日 11:10
全套基因检测只要39.9,这家创业公司是怎么做到的?
2021年04月29日 23:06

北大创业者最爱在哪里创业?
2021年04月29日 14:23
创新工场李开复:泡沫可怕,创业融不到钱而死亡更可怕
2021年04月28日 16:41

北大工程师海外变身网红“菜农”,异国创业路上的年轻人都在“玩”些啥
2021年04月27日 18:29

投资人朱啸虎:给创业者和新品牌的五大建议
2021年04月26日 11:19
创业者如何让公司持续获得融资?
2021年04月25日 20:07
利用AI为企业提供数据管理解决方案平台,「九章数据」2021年营收将达近亿元,增长5倍以上 | 新科技创业2021
2021年04月22日 18:55

36氪招聘 | 将自己的成长看成一次创业,高增长性才是最为重要的数据指标
2021年04月21日 15:45

深度对话:早期创业公司,如何识人断人,打造高效组织?
2021年04月21日 10:33
首届“数博会”招商招展工作取得重大进展
2021年04月19日 12:22

36氪首发 | 共享童车「熊猫遛娃」完成千万元级A轮融资,好孩子创业发展基金和中汇金资本联合领投
2021年04月19日 09:00

如何科学预测创业公司未来的成败?
2021年04月16日 16:32

19 岁华裔天才辍学创业,5 年市值达 73 亿美元
2021年04月16日 16:25

十年前的创业第一天,我走下了28楼
2021年04月16日 14:12
国家政策利好公司业务,「源清慧虹」推中台拓展客户 | 新科技创业2021
2021年04月15日 08:01

- 1问界商标转让释放信号:赛力斯 95792
- 2报告:抖音海外版下载量突破1 25736
- 3人类唯一的出路:变成人工智能 25175
- 4人类唯一的出路: 变成人工智 24611
- 5移动办公如何高效?谷歌研究了 24309
- 6华为 nova14深度评测: 13155
- 7滴滴出行被投诉价格操纵,网约 11888
- 82023年起,银行存取款迎来 10774
- 9五一来了,大数据杀熟又想来, 9794
- 10手机中存在一个监听开关,你关 9519
科技快讯热点排名
科技快讯热点






